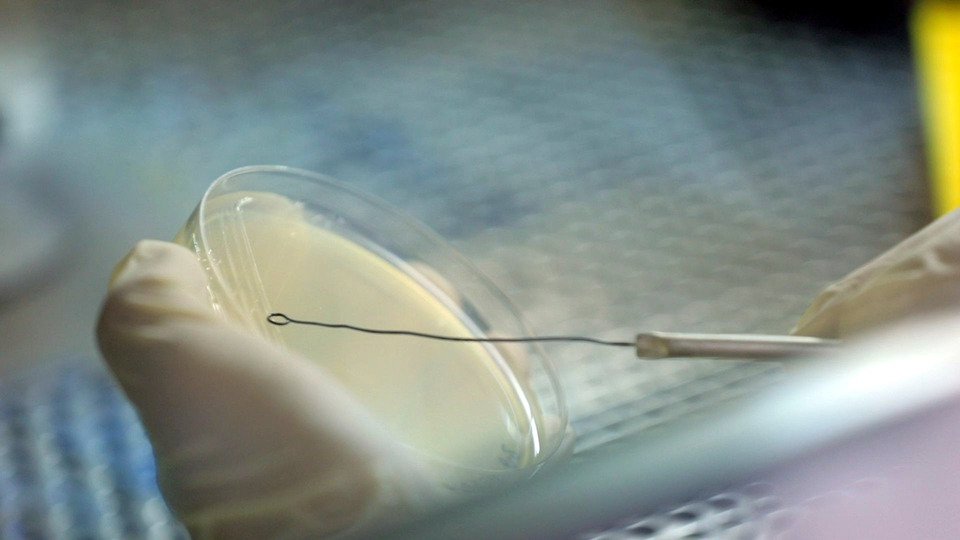

ปุ๋ยชีวภาพพีจีพีอาร์-วัน นวัตกรรมจุลินทรีย์เพื่อเกษตรยั่งยืน จากกลุ่มวิจัยปฐพีวิทยา กองวิจัยพัฒนาปัจจัยการผลิตทางการเกษตร กรมวิชาการเกษตร
ภายใต้ความผันผวนของสภาพภูมิอากาศ ต้นทุนการผลิตที่สูงขึ้น และข้อจำกัดด้านทรัพยากรดิน วันนี้ เกษตรกรไทยกำลังยืนอยู่บนจุดเปลี่ยนสำคัญ จุดเปลี่ยน จากการพึ่งพาปุ๋ยเคมีเพียงอย่างเดียว สู่การใช้เทคโนโลยีชีวภาพ เพื่อเพิ่มประสิทธิภาพ ลดต้นทุน และดูแลผืนดินอย่างยั่งยืน
กรมวิชาการเกษตร จึงมีแนวทางในการพัฒนากลุ่มแบคทีเรียอัจฉริยะที่อาศัยอยู่บริเวณรอบรากข้าว ที่เรียกว่า Plant Growth-Promoting Rhizobacteria หรือ PGPR ซึ่งเป็นกุญแจสำคัญของปุ๋ยชีวภาพยุคใหม่ และศึกษาการใช้ปุ๋ยชีวภาพ พีจีพีอาร์-วัน กับการผลิตข้าวโพดข้าวเหนียวพันธุ์สวีทไวท์ 25 และชัยนาท 2 ในพื้นที่เกษตรกรจังหวัดชัยนาท ซึ่งเป็นดินที่มีความอุดมสมบูรณ์ปานกลาง โดยการทดลองวางแผนแบบ Randomized Complete Block จำนวน 4 ซ้ำ 5 กรรมวิธี เปรียบเทียบการใช้ปุ๋ยเคมีตามค่าวิเคราะห์ดินร่วมกับปุ๋ยชีวภาพพีจีพีอาร์-วัน 2 รูปแบบ ทั้งในอัตรา 100% และลดปุ๋ยเคมีลง 25%” ผลการทดลอง 2 ปี พบว่า ผลผลิตข้าวโพดทั้งสองพันธุ์ ไม่แตกต่างกันในช่วงเวลาสำคัญของการใส่ปุ๋ยในปีแรก ให้ผลผลิตดีกว่าปีที่สองและแม้การใช้พีจีพีอาร์-วัน จะช่วยลดการใช้ปุ๋ยเคมีได้ 25% แต่เมื่อคำนวณผลตอบแทนทางเศรษฐกิจค่า VCR ยังต่ำกว่าค่าวิกฤต 2.00

นายกิตติธร ศรีประภา นักวิชาการเกษตร กลุ่มวิจัยปฐพีวิทยา กองวิจัยพัฒนาปัจจัยการผลิตทางการเกษตร กรมวิชาการเกษตร เปิดเผยว่า PGPR 1 หรือ Plant Growth-Promoting Rhizobacteria คือ กลุ่มแบคทีเรียที่อาศัยอยู่รอบ ๆ รากพืชและช่วยกระตุ้นการเจริญเติบโตโดยการตรึงไนโตรเจน หรือ ผลิตฮอร์โมนพืชประกอบด้วยเชื้อ Azospirillum แยกมาจากตัวรากหญ้าแฝก Azotobacter แยกมาจากรากข้าวโพด และ Beijerinckia แยกมาจากรากข้าวโพด จะเป็นจุลินทรีย์ส่งเสริมบริเวณรอบรากให้กับพืชตระกูล ข้าวโพด ข้าวฟ่าง พืชผักสมุนไพร ในตัวของ PGPR 1 ที่มีการผลิคปุ๋ยชีวภาพขึ้น

จากการวิเคราะ ทดลอง วิจัย จึงสะท้อนให้เห็นว่า ปุ๋ยชีวภาพพีจีพีอาร์-วัน เป็นเทคโนโลยีที่มีศักยภาพ แต่ยังจำเป็นต้องมีการศึกษาเพิ่มเติมในระยะยาว ทั้งด้านผลผลิต เศรษฐศาสตร์ และการยอมรับของเกษตรกร โดยตลอดการดำเนินงานมีการถ่ายทอดองค์ความรู้สู่เกษตรกร ซึ่งผ่านการฝึกอบรม การสาธิต และเวทีเสวนาในพื้นที่จริง ผลลัพธ์ไม่ใช่เพียงตัวเลขผลผลิต แต่คือการยอมรับเทคโนโลยี และการต่อยอดองค์ความรู้ให้เหมาะสมกับพื้นที่ของตนเอง ปุ๋ยชีวภาพพีจีพีอาร์-วัน คือ อีกหนึ่งนวัตกรรมที่สะท้อนบทบาทของกรมวิชาการเกษตร ในการวิจัย พัฒนา และพิสูจน์เทคโนโลยีอย่างเป็นระบบ แม้งานวิจัยบางด้าน ยังต้องการการศึกษาเพิ่มเติม แต่บทเรียนจากอ้อยและมันสำปะหลังได้แสดงให้เห็นถึงศักยภาพของจุลินทรีย์ในการเพิ่มผลผลิต ลดต้นทุน และดูแลผืนดินให้มีประสิทธิภาพมากขึ้น จากห้องปฏิบัติการ สู่แปลงเกษตร จากองค์ความรู้ สู่การเปลี่ยนแปลงที่จับต้องได้ นี่คือภารกิจของกรมวิชาการเกษตร เพื่อเกษตรกรไทย และความมั่นคงทางอาหารของประเทศ เพราะดินที่ดี คือ จุดเริ่มต้นของพืช ในอนาคตอย่างยั่งยืน

“อยากจะแนะนำให้เกษตรกร เก็บปุ๋ยในอุณหภูมิห้องเย็นที่ 6 องศา หรือตู้เย็น เพื่อจะทำให้ปุ๋ยชีวภาพคงคุณภาพ เพราะเป็นจุลินทรีย์ที่มีชีวิต ส่งเสริมให้พืชของพี่-น้องเกษตรกรมีประสิทธิภาพมากยิ่งขึ้น แต่ถ้าเก็บที่อุณหภูมิที่ร้อน จะส่งผลให้ปุ๋ยชีวภาพ อาจจะส่งเสริมประสิทธิภาพไม่ดีเท่าที่ควร” กิตติธร กล่าวทิ้งท้าย
สอบถามข้อมูลเพิ่มเติมได้ที่หน่วยงานของกรมวิชาการเกษตร กลุ่มวิจัยปฐพีวิทยา กองวิจัยพัฒนาปัจจัยการผลิตทางการเกษตร กรมวิชาการเกษตร โทรศัพท์ 0-2579-7522-3, 0-2579-4116 E-mail: soilscience2560@gmail.com







